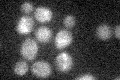
YKL094W

View description
Serine hydrolase with sequence similarity to monoglyceride lipase (MGL), localizes to lipid particles
Localization:
Intensity:
Fold change:
Significance:
-
C’ GFP library in SD

below threshold15.36 -
N' NOP1pr-GFP in SD

cell periphery,ER126.772 -
N' TEF2pr-mCherry in SD

cell periphery,ER241.716 -
N' NATIVEpr-GFP in SD

ER54.7842 -
N' TEF2pr-VC and Cyto-VN in SD

ER40.1029 -
C’ GFP library in SD+DTT

cytosol16.781.09No -
C’ GFP library in SD+H2O2
cytosol18.431.19No -
C’ GFP library in Starvation Media

cytosol17.091.11No -
C’ GFP library on the background of Pup2-DaMP

below threshold -
C’ GFP library on the background of CCT mutant

below threshold18.61191.2108No
